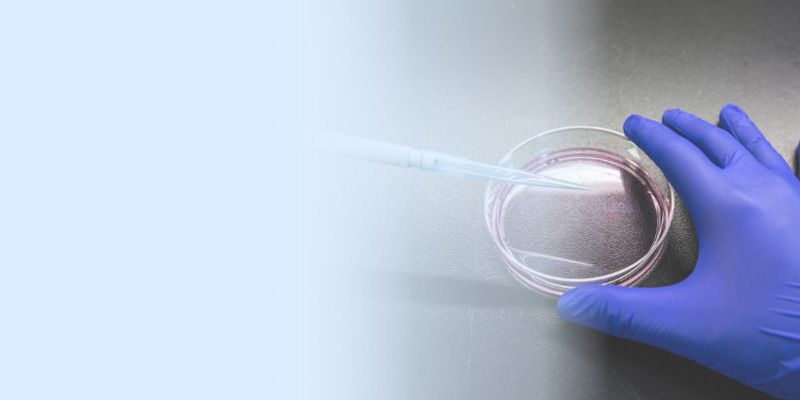
Gloved hand holding petri dish

Cell & Tissue Culture: Centralized Procurement for Research Teams
ZAGENO’s digital lab supply platform centralizes cell culture procurement, helping teams manage supplier access, standardize purchasing, and unify ordering across thousands of vendors. Optimize your sourcing to ensure workflow consistency and minimize supply disruptions.
Centralized Cell Culture Procurement and Tissue Culture Sourcing
Access cell culture supplies and tissue culture products from leading global suppliers through a single, integrated system. Compare real-time availability, review lead times, and standardize the purchasing of materials for both routine culture work and advanced cell-based research. ZAGENO provides full visibility and control over your reagents, ensuring your team isn’t slowed down by fragmented vendor data.

Biological Tissues
Cell Culture
Cells and Microorganisms

How Centralized Procurement Supports Reliable Research
ZAGENO integrates cell culture reagent procurement into a single digital ecosystem. By consolidating vendors, automating approval workflows, and standardizing ordering, teams reduce variability and improve transparency across R&D, procurement, and finance operations.

Reclaim Research Time with a Consolidated Sourcing Workflow
Replace fragmented supplier portals with a dedicated lab procurement platform for cell culture. Gain instant access to availability data and streamlined supplier onboarding. ZAGENO simplifies reagent sourcing so scientists can focus on discovery than administrative hurdles.
Cell Culture Suppliers: Connected via One Procurement Platform
Access thousands of suppliers through ZAGENO’s centralized management workflow, including Milipore Sigma, ATCC, Cytiva, and more. View lead times directly in the platform while consolidating your cell culture purchasing across a diverse vendor landscape.






Cell & Tissue Culture Procurement Through ZAGENO
ZAGENO centralizes cell culture procurement by connecting labs to over 40M SKUs from 5,300+ suppliers in one digital platform. Research teams can compare availability, standardize purchasing, and manage reagent sourcing workflows through one unified system.
Yes. ZAGENO supports centralized supplier management, allowing labs to consolidate their vendor list while maintaining access to specialized cell culture media, cell lines, and primary cells.
Yes. Built-in approvals, consolidated invoicing, and configurable rules help streamline cell culture purchasing across multiple departments and locations.
By standardizing ordering and preventing untracked supplier substitutions, centralized sourcing ensures that your team uses consistent materials across every phrase of an experiment.
Access 50,000,000 Products in One Shop!
Trusted by thousands of scientists, lab managers, procurement and finance teams, ZAGENO's marketplace will help you search and order quickly in one go. Reach out for a demo today!